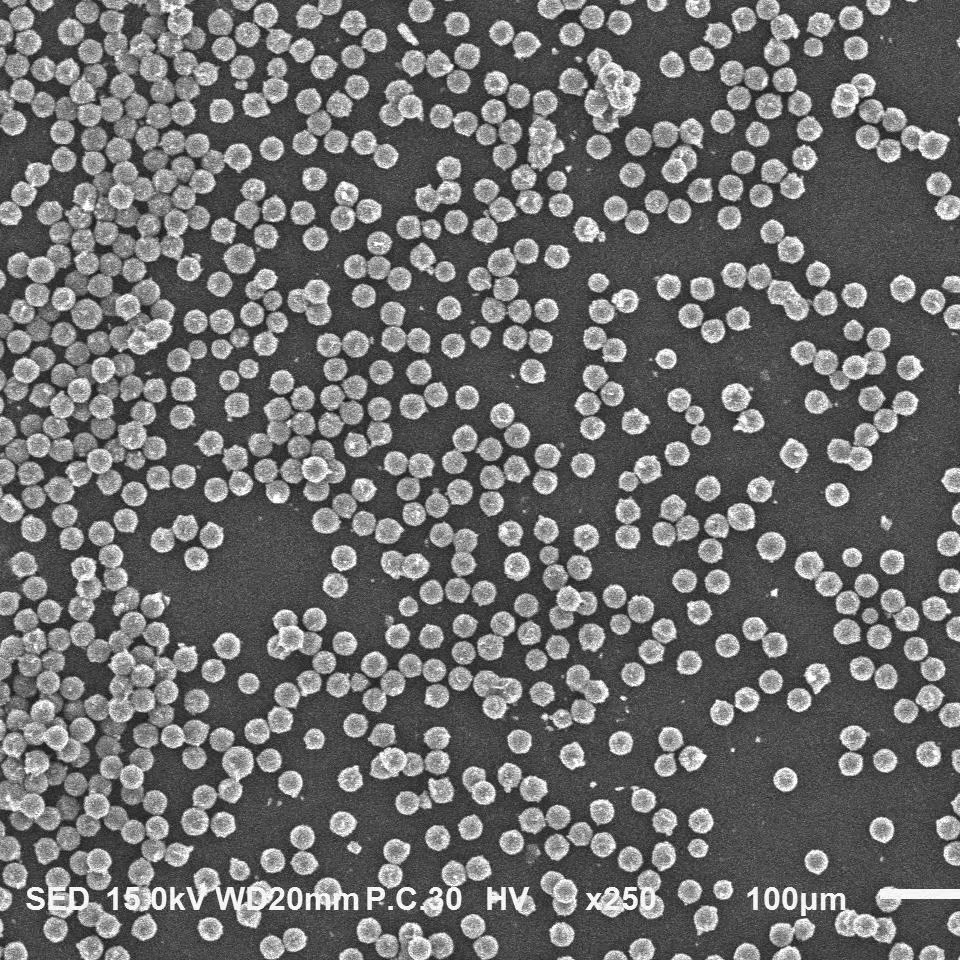

全部24个规格
| 颜色分类 | 售价 | 原价 | 库存 | 重量 | 体积 | 编码 | 条码 | 购买数量 | 操作 |
|---|---|---|---|---|---|---|---|---|---|
| 10毫升 2.5%固含量25mg/ml | ¥ 登录可见 | ¥ 登录可见 | 9999 件 | 652554224260 |
|
||||
| 10毫升 5%固含量50mg/ml | ¥ 登录可见 | ¥ 登录可见 | 9999 件 | 652554224260 |
|
||||
| 10毫升 10%固含量100mg/ml | ¥ 登录可见 | ¥ 登录可见 | 9999 件 | 652554224260 |
|
||||
| 20毫升 2.5%固含量25mg/ml | ¥ 登录可见 | ¥ 登录可见 | 9999 件 | 652554224260 |
|
||||
| 20毫升 5%固含量50mg/ml | ¥ 登录可见 | ¥ 登录可见 | 9999 件 | 652554224260 |
|
||||
| 20毫升 10%固含量100mg/ml | ¥ 登录可见 | ¥ 登录可见 | 9999 件 | 652554224260 |
|
||||
| 50纳米 2.5% 10毫升25mg/ml | ¥ 登录可见 | ¥ 登录可见 | 9999 件 | 652554224260 |
|
||||
| 100纳米 2.5% 10毫升25mg/ml | ¥ 登录可见 | ¥ 登录可见 | 9999 件 | 652554224260 |
|
||||
| 200纳米 2.5% 10毫升25mg/ml | ¥ 登录可见 | ¥ 登录可见 | 9999 件 | 652554224260 |
|
||||
| 500纳米 2.5% 10毫升25mg/ml | ¥ 登录可见 | ¥ 登录可见 | 9999 件 | 652554224260 |
|
||||
| 1微米 2.5% 10毫升25mg/ml | ¥ 登录可见 | ¥ 登录可见 | 9999 件 | 652554224260 |
|
||||
| 2微米 2.5% 10毫升25mg/ml | ¥ 登录可见 | ¥ 登录可见 | 9999 件 | 652554224260 |
|
||||
| 5微米 2.5% 10毫升25mg/ml | ¥ 登录可见 | ¥ 登录可见 | 9999 件 | 652554224260 |
|
||||
| 10微米 2.5% 10毫升25mg/ml | ¥ 登录可见 | ¥ 登录可见 | 9999 件 | 652554224260 |
|
||||
| 20微米 2.5% 10毫升25mg/ml | ¥ 登录可见 | ¥ 登录可见 | 9999 件 | 652554224260 |
|
||||
| 50微米 2.5% 10毫升25mg/ml | ¥ 登录可见 | ¥ 登录可见 | 9999 件 | 652554224260 |
|
||||
| 100微米 2.5% 10毫升25mg/ml | ¥ 登录可见 | ¥ 登录可见 | 9999 件 | 652554224260 |
|
||||
| 羧基化磁珠 10毫升 2.5%固含量25mg/ml | ¥ 登录可见 | ¥ 登录可见 | 9999 件 | 652554224260 |
|
||||
| 氨基化磁珠 10毫升 2.5%固含量25mg/ml | ¥ 登录可见 | ¥ 登录可见 | 9999 件 | 652554224260 |
|
||||
| 1克磁珠粉末 | ¥ 登录可见 | ¥ 登录可见 | 9999 件 | 652554224260 |
|
||||
| 巯基化磁珠 10毫升 2.5%固含量25mg/ml | ¥ 登录可见 | ¥ 登录可见 | 9999 件 | 652554224260 |
|
||||
| 疏水油酸修饰磁珠 10毫升 2.5%固含量25mg/ml | ¥ 登录可见 | ¥ 登录可见 | 9999 件 | 652554224260 |
|
||||
| 油酸修饰磁珠250毫克(备注尺寸) | ¥ 登录可见 | ¥ 登录可见 | 9999 件 | 652554224260 |
|
||||
| Tosyl功能化磁性微球 10毫升 10毫克每毫升 | ¥ 登录可见 | ¥ 登录可见 | 9999 件 | 652554224260 |
|

没有相关规格
已选
0
种
0
件
金额:
¥0.00
看了又看